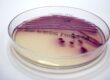

Three blood groups are regularly described in cats. The AB blood group system is comparable to the ABO system used in humans. There are, however, only three blood groups: A, B, and AB. Blood group AB has recently been renamed C since it does not occur due to a normal cross between A and B.
Most cats have blood group A. For some breeds, such as Siamese cats, all members have blood group A, for others, up to half of the population are blood group B. Blood group C is very rare, about 0.7% of the animals in Germany have this blood group.
European Shorthair and American Short- and Longhair cats are predominantly blood group A. The percentage of animals with this blood group varies geographically between 74 and 100%. In Germany, the percentage of A cats of these breeds has been reported to be 94%, but is slightly lower in our experience.
The incidence of blood group B is very variable in different breeds of cats. No blood group B animals have ever been described among Siamese cats. Approximately 1-10% of Maine Coon and Norwegian Forest Cats, 11-20% of Abessinians, Somali, Birman, Persian, Scottish Fold, and 20-45% of Exotic Shorthair, British Shorthair, Cornish Rex, and Devon Rex cats are type B cats.
Purebred Turkish Van cats are even 60% type B. (Tab. 1)
- Tab 1: Purebred Turkish Van cats are even 60% type B.
- Fig. 1: new genetics tests for feline blood groups
Genetics
Blood groups are generally inherited with two traits by an autosomal dominant pathway in which A is dominant over b. Cats with blood group A can either be homozygous (A/A) or heterozygous (A/b). Animals with blood group B are always homozygous for allele b (b/b). If an animal has two copies of variant aC (aC/aC) or one together with the b allele (aC/b), the cat has blood group C.
The blood group is determined by differences in neuraminic acids on the surface of the erythrocytes, whereby N-gylcolylneuraminic acid is the A antigen and N-acetylneuraminic acid is the B antigen. Cats with blood group C have both neuraminic acids in the erythrocytic membrane.Cats have natural alloantibodies against the heterologous blood group. Cats with blood group B produce high levels of anti-A antibodies. Cats with blood group A, however, have only low anti-B antibody titers (Fig. 1).
Blood transfusion
These alloantibodies are responsible for the occurrence of acute hemolytic transfusion reactions. Cats with blood group A should therefore only receive A blood, cats with blood group B only B blood and cats with blood group C should only receive A or C blood. Transfusion of the wrong blood type can cause blood group incompatibility, which can be lethal, the first time it is carried out. Additional erythrocyte antigens, such as the so called Mik antigen, have also been described recently. There are no tests for this at the moment, but since these can also cause blood transfusion incompatibility, a cross match test (test for possible agglutination = incompatibility by mixing donor erythrocytes with recipient serum and recipient erythrocytes with donor serum) should always be done in the practice even for cats with compatible blood groups.
Neonatal isoerythrolysis
An additional incompatibility reaction that is especially important for breeders is neonatal isoerythrolysis (NI). It occurs when blood group B queens are bred by blood group A toms. Since A is dominant over b, kittens from these couplings are either all (if the tom cat is genetically AA), or to 50% (if the tom cat is Ab) blood group A. These kittens receive anti-A antibodies from the mother in the colostrum, causing erythrocyte lysis, which can lead to the death of the kittens. It is therefore important to determine the blood group of breeding cats, especially for breeds in which blood group B is common. Studies determining the antibody titers of anti-A in B queens have shown that even low titers can cause NI. If cats with these blood groups are bred anyway, the kittens should not be given any colostrum or milk from the mother within the first 36 hours of life.
Blood group determination
A serological determination of the blood group is usually done as the first step. This is also called the phenotypical blood group, i.e. the blood group that should be determined before a transfusion or breeding. This typing has been offered by Laboklin and other laboratories for many years and Laboklin also offers point of care test kits.
The genetic determination of the blood group in cats also allows a genetic differentiation (genotype) of the serologically determined blood group. This method allows the identification of the recessive b allele in A cats, since genetically, A cats can by homozygous AA or heterozygous Ab carriers. If two heterozygous Ab carriers are bred, they could produce homozygous b kittens.
Genetic variations in the CMAH gene were first found to be associated with blood groups A and B in 2007. This finding led to the development of genetic tests to determine the genetic blood group. However, these were repeatedly associated with differences between the genetic variants and the actual blood group. Results were not always reliable, especially for the breeds Turkish Angora and Van, Ragdoll, Siberian, and Neva Masquerade, so that testing was not offered for these breeds by most laboratories.
Laboklin recently carried out a large scale study to address this problem. 450 cats were tested both serologically and genetically. This showed that the genetic variations responsible for blood group B are breed specific. The variant found in Turkish Angora cats, for example, is different from that found in Norwegian Forest cats. By modifying the testing accordingly, it was possible to significantly improve it.
The previous test reliability of about 70% for e.g. Ragdoll, Turkish Angora, and Siberian cats has now been increased to the same level as that of other breeds thanks to the new Laboklin DNA test. This test can therefore now be considered highly reliable for these breeds as well as others. This is an important clinical improvement of the detection methods available.
The genetic cause of the marked presence of blood group C in Ragdolls was also determined in 2016. It is therefore also possible to determine genetic blood group C (previously known as AB) in Ragdolls.